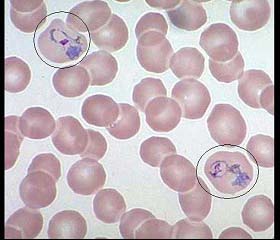

A.卡波环
B.嗜碱性点彩红细胞
C.H-J小体
D.网织红细胞
E.疟原虫
[单选题]如图,圈中所示红细胞中的异常结构为()A.卡波环B.嗜碱性点彩红细胞C.H-J小体D.网织红细胞E.疟原虫
[单选题]图所示细胞为()A.点彩红细胞B.网织红细胞C.嗜多色红细胞D.红细胞着色不一E.白细胞
[单选题]如图箭头所示为大脑哪个部位()A.中央前回B.旁中央小叶C.中央后回D.枕叶E.额叶
[单选题]图中所示红细胞异常结构为()A.H-J小体B.杜勒小体C.嗜碱性点彩红细胞D.疟原虫E.网织红细胞
[单选题]图中所示红细胞异常结构为()A.H-J小体B.杜勒小体C.嗜碱性点彩红细胞D.疟原虫E.网织红细胞
[多选题]如图所示的异常红细胞结构为()A.嗜碱性点彩红细胞B.H-J小体C.网织红细胞D.疟原虫E.卡波环
[多选题]如图所示的异常红细胞结构为()A.嗜碱性点彩红细胞B.H-J小体C.网织红细胞D.疟原虫E.卡波环
[多选题]如图所示的异常红细胞结构为()A.嗜碱性点彩红细胞B.H-J小体C.网织红细胞D.疟原虫E.卡波环
[多选题]如图所示的异常红细胞结构为()A.嗜碱性点彩红细胞B.H-J小体C.网织红细胞D.疟原虫E.卡波环
[单选题]如图(革兰染色)所示微生物为:()A.革兰阳性球菌B.革兰阴性球菌C.革兰阳性杆菌D.革兰阴性杆菌E.酵母样真菌